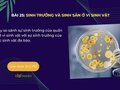
So sánh sự sinh trưởng của quần thể vi sinh vật với sự sinh trưởng

Vẽ và giải thích đường cong sinh trưởng trong nuôi cấy liên tục
Hãy vẽ và giải thích đường cong sinh trưởng trong nuôi cấy liên tục. Trả lời câu hỏi 4 trang 120 sách giáo khoa Sinh học 10 Chân trời sáng tạo

 Bộ môn: Văn
Bộ môn: Văn Lớp: 12
Lớp: 12
Hãy vẽ và giải thích đường cong sinh trưởng trong nuôi cấy liên tục. Trả lời câu hỏi 4 trang 120 sách giáo khoa Sinh học 10 Chân trời sáng tạo

Đọc thông tin trên và quan sát Hình 25.3, hãy trình bày đặc điểm các pha sinh trưởng của quần thể vi khuẩn trong nuôi cấy không liên tục.
Hãy so sánh sự sinh trưởng của quần thể vi sinh vật với sự sinh trưởng của các sinh vật đa bào. Trả lời câu hỏi luyện tập 1 trang 119 sách giáo khoa Sinh học 10 CTST

Vì sao nói sinh trưởng ở vi sinh vật là sinh trưởng của quần thể? Trả lời câu hỏi 2 trang 119 sách giáo khoa Sinh học 10 Chân trời sáng tạo

Dựa vào Hình 25.2, hãy nhận xét số lượng tế bào vi khuẩn E. coli sau mỗi lần phân chia. Từ đó, hãy cho biết khái niệm sinh trưởng ở vi sinh vật.

Cho ví dụ cụ thể để phân biệt lên men lactic đồng hình và dị hình ở vi sinh vật. Trả lời câu hỏi 3 trang 118 sách giáo khoa Sinh học 10 CTST

Trình bày vai trò của vi sinh vật trong đời sống con người và trong tự nhiên thông qua các hoạt động tổng hợp và phân giải các chất (carbohydrate, protein, lipid)

Nêu một số ví dụ thực tiễn về quá trình tổng hợp và phân giải các chất ở vi sinh vật. Trả lời câu hỏi 1 trang 118 sách giáo khoa Sinh học 10 CTST

Hãy thiết kế một sản phẩm học tập (mô hình, poster, tập san,...) trình bày về vai trò của vi sinh vật đối với tự nhiên và đời sống con người.

Lập bảng trình bày điểm chung và riêng của các quá trình phân giải ở vi sinh vật. Trả lời câu hỏi luyện tập 2 trang 116 sách giáo khoa Sinh học 10 CTST